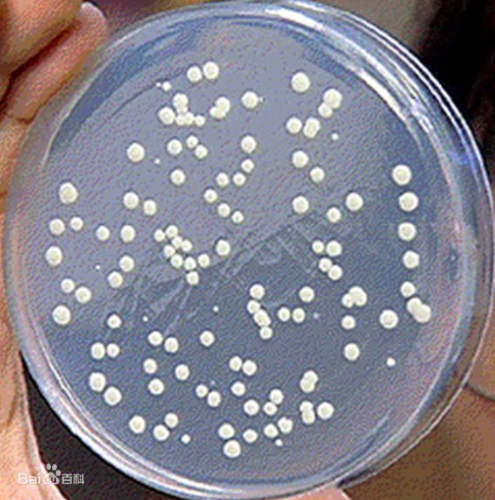
微生物 微生物知识点精选自整的，含852微生物的重点，干货满满！
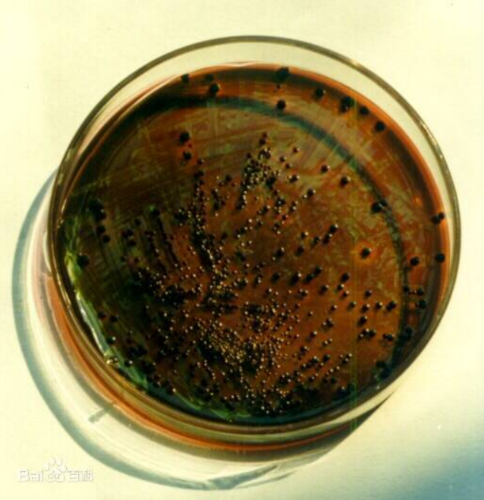
微生物 微生物知识点精选自整的，含852微生物的重点，干货满满！

文章图片

文章图片
文章图片

文章图片
文章图片

文章图片

微生物——[禁止转载 , 违者必究】●资料整理
●微生物 , 各大菌类的图片 , 与人类、医学、食品相关的利弊初步进行整理 , 并针对其特定知识点进行不断地深化层次挖掘 , 视频!
●进行全面覆盖式的微生物分析.
●大题考点
●绪论★★
●微生物的五大共性
●体积小 , 面积大、吸收多 , 转化快、生长旺 , 繁殖快、适应强 , 易变异、种类多 , 分布广
●主要是体积小 , 面积大 。
●微生物的种类多体现在
●<1>物种的多样性
●<2>生理代谢类型的多样性
●<3>代谢产物的多样性
●<4>遗传基因的多样性
●<5>生态类型的多样性
●微生物学对人类发展的促进作用【没有找到适合的】
●
●第一章——原核生物的形态、构造和功能★★★
●革兰氏染色的原理机制、步骤
●机制
●通过结晶紫初染和碘液媒染后 , 在细菌的细胞膜内可形成不溶于水的结晶紫与碘的复合物 。 G+细菌由于其细胞壁较厚、肽聚糖网层次多和交联致密 , 故遇脱色剂乙醇处理时 , 因失水而使网孔缩小 , 在加上它不含类脂 , 故乙醇的处理不会溶出缝隙 , 因此能把结晶紫与碘的复合物牢牢留在壁内 , 使其保持紫色 。 反之 , G-细菌因其细胞壁薄、外膜层类脂含量高、肽聚糖层薄和交联度差 , 遇脱色剂乙醇后 , 以类脂为主的外膜迅速溶解 , 这时薄而松散的肽聚糖网不能阻挡结晶紫与碘复合物的溶出 , 因此细胞退成无色 。 这时 , 在经沙黄等红色染料复染 , 就使G-细菌呈红色 , 而G+细菌则仍保留最初的紫色 。
●步骤
●①涂片:在干净的载玻片上滴一滴水 , 用接种环挑取菌体均匀涂布于水中 。
●②固定:将玻片靠近酒精灯火焰 , 蒸干水分 , 但不要烤焦 。
●③初染:用碱性颜料结晶紫对菌液涂片进行初染 。
●④媒染: 以碘液媒染1min , 水洗 , 吸干水分 。 (细胞内形成结晶紫与碘的复合物 , 增强相互作用)
●⑤脱色(关键步骤):以95%的乙醇脱色30s , 应适当振荡均匀 , 是乙醇脱色完全 。
●⑥水洗 , 吸干 。
●⑦复染:复染30s , 水洗吸干 。
●⑧干燥镜检
●G+与G-菌细胞壁的异同
●G+特有——磷壁酸(外毒素)
●紫色
●G-特有——脂多糖(内毒素)
●红色
●四种缺壁细菌
●L型细菌(G-)
●无壁
●实验室中 , 人工
●支原体(G+)(含有一般原核生物没有的甾醇以使其细胞壁有较强的机械强度)
●完全无壁
●自然进化 , 人工
●球状体
●部分缺壁
●溶菌酶去壁或青霉素抑制肽聚糖合成
●原生质体
●基本无壁
●溶菌酶去壁或青霉素抑制肽聚糖合成
●鞭毛的观察方法
●半固体琼脂柱穿刺接种培养后观察
●穿刺线周围若有浑浊的扩散区 , 则证明该菌有运动能力 , 即可推测其有鞭毛 , 如图右边的试管
●平面培养基上的菌落外形推断
●产鞭毛菌运动能力很强、其菌落很大、薄、不规则、边缘极不整齐
●光学显微镜下观察 , 鞭毛染色使其变粗易于观察
●如图
●电子显微镜下直接观察
●如图
●细菌、放线菌、酵母菌和霉菌间菌落特征的比较
●芽孢、抗逆机制渗透调节皮层膨胀学说★
●提出芽孢的耐热性:在于芽孢衣对多价阳离子和水分的透性差 , 而其皮层含有大量带负电荷的肽聚糖 , 其离子强度很高 , 从而使皮层产生极高的渗透压去夺取芽孢核心部位的水分 , 其结果造成了皮层的充分膨胀 , 而芽孢的核心部位却高度失水 , 从而使其获得了高度耐热性 。
推荐阅读
- 既然琥珀能保昆虫万年不腐,古人为何不用琥珀来给尸体做防腐?
- 一场火在地球上烧了50年,平均每年造成500亿损失,至今无法扑灭
- 深入地了解地球上的土壤、水和空气,有助于寻找新生命
- ?冰和岩石栖息地中现存的垫子世界
- ?尤卡坦半岛的大量微生物
- 新冠病毒最终可能走向“静默”与人类共存
- 50万年前,北京猿人没能爬到食物链顶端,却成了蚕食同类的恶魔
- 在能把人烤焦的温度下,“深层生物圈”里的生命却能茁壮成长
- 昆仑山真有神仙在渡劫飞升?科学家不相信,但游客却拍到一张照片
- 地球果然出了问题?海底2000米处异象突现,71亿人要遭殃了
